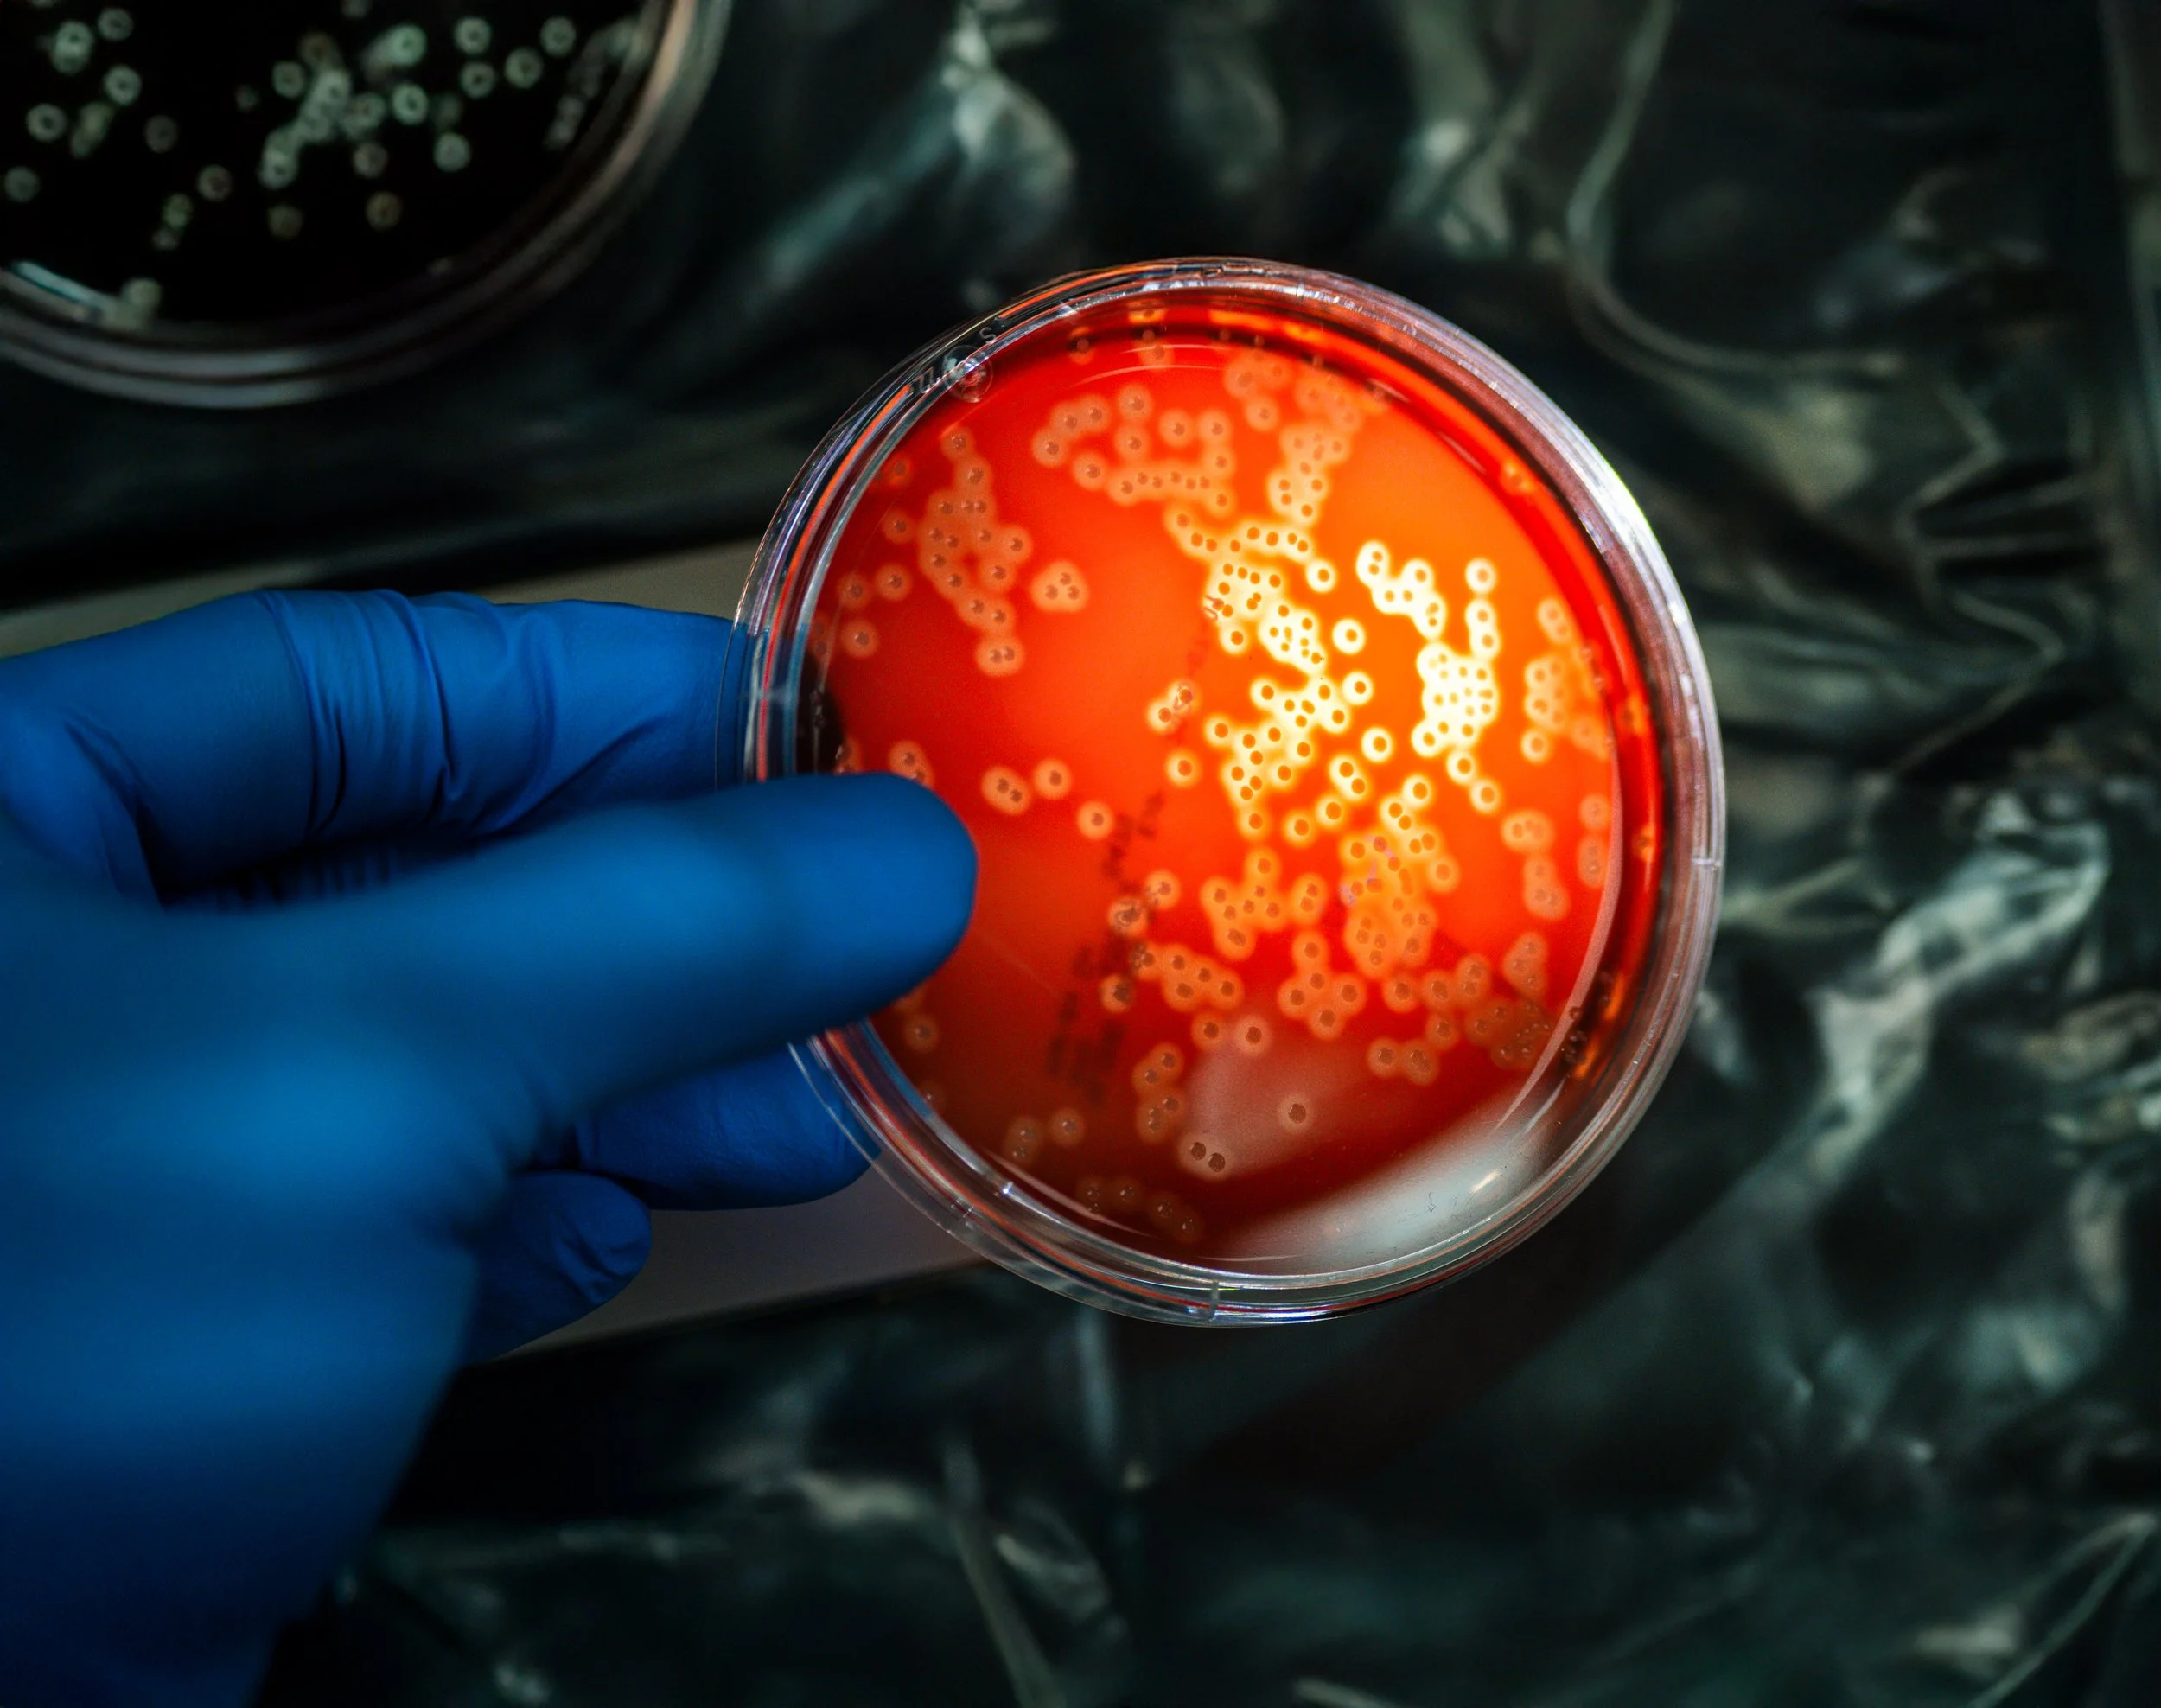

Invisible Worlds. Monumental Impact.
A cinematic exploration of bacteria, born from deep reverence for the invisible worlds that shape us all
Invisible Worlds. Monumental Impact.
A cinematic exploration of bacteria, born from deep reverence for the invisible worlds that shape us all
Discover the Hidden Beauty of Bacteria and Viruses
Explore the unseen beauty of bacteria, viruses, and the microbial universe through a visual journey that blends generative AI, cinematic design, and real-world public health narratives. Whether you're a scientist, student, or simply curious—this series invites you to pause, reflect, and engage.
the dense moss, rich with moisture, is a perfect growing medium for iceland’s many species of mushrooms. experienced mushroom hunters know to visit their favorite spots a few days after it rains to find the biggest variety.
Not Just Beautiful—Biologically Grounded
iceland’s geothermic pools and black sand beaches create stunning compositions from the air. both are created by the island’s constant volcanic activity.

natural beauty in its rawest form
iceland’s surface is carved by water, originating from either its massive glaciers or abundant rainfall.
the sun’s angle at this latitude produces deep and contrasty colors, drawing out the blacks in the volcanic soil and saturating the greens from the grasses and moss.
shop prints
a2 sized digital c prints, suitable for framing. each edition is limited to ten prints.